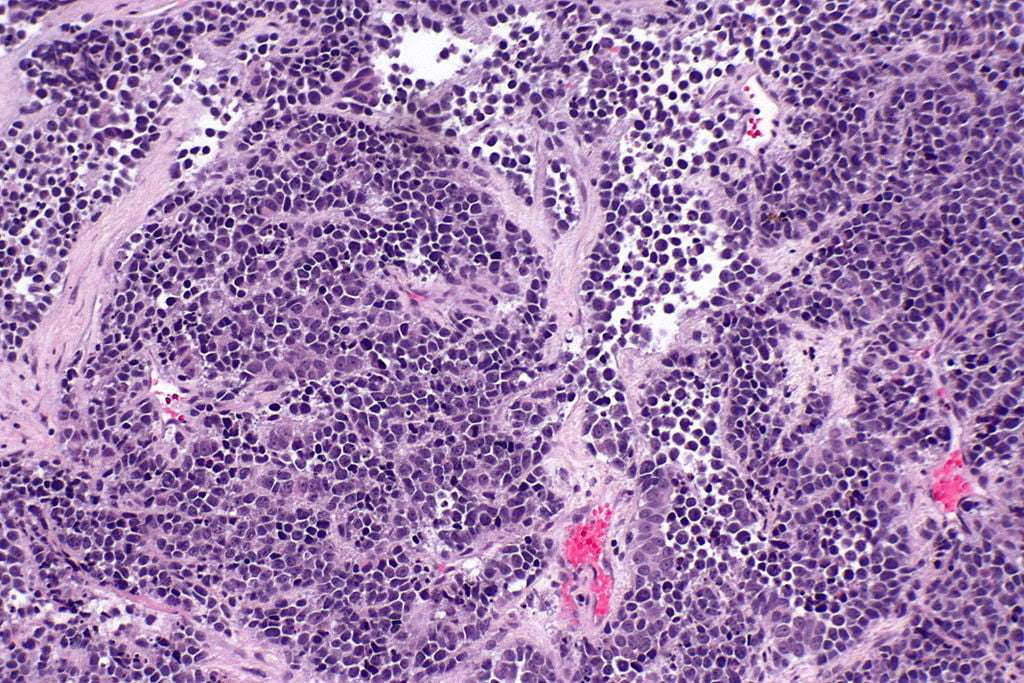
cancer de vezica

Cancerul de vezica reprezinta cumulul de tumori maligne care pot aparea la nivelul pielii vezicii urinare. Putine sunt cazurile in care pe suprafata pielii din jurul vezicii apar tumori non-maligne, acestea nefiind incluse in randul cancerelor de vezica. Vezica urinara este, de fapt, containerul in care se tine urina inainte de a iesi prin intermediul mictiunii. Acest organ muscular poate fi afectat de celulele anormale care se multiplica fara control in interiorul sau. Studiile arata ca nu mai putin de 400 de mii de oameni sufera de forme de cancer la vezica urinara in intreaga lume.
Primul simptom al acestei afectiuni este aparitia sangelui in urina, care poate fi observata de bolnav sau cu ajutorul testului la microscop al urinei. Asta nu este insa tot, bolnavul putand avea si dureri in timpul urinarii, poate avea urinari mult mai dese, sau poate sa aiba senzatia de urinare fara rezultat vizibil.
Simptomele pe care bolnavul de cancer de vezica le poate avea nu sunt specifice acestei boli, astfel ca si alte boli pot fi asociate, in timp, cu simptomatologia generala a cancerului. Printre afectiunile ce se pot dezvolta la nivelul tractului urinar se afla cistita si prostata sau chiar cancerul de rinichi.
Simptomele care prezinta mai clar aparitia cancerului de vezica sunt durerile lombare sau de flanc, tumorile din zona vezicii si umflarea excesiva a picioarelor.
Care sunt cauzele bolii?
Printre cauzele cancerului de la vezica urinara se afla fumatul, actiune nociva ce contribuie la aparitia tuturor tipurilor de cancer. Persoanele care se hidrateaza zilnic au o incidenta scazuta a aparitiei cancerului, pe cand chiar vezica urinara se poate transforma intr-o cauza a cancerului, avand in vedere ca aceasta poate lua carcinogeni din timpul urinarii, chiar din urina.
Persoanele care sunt expuse la carcinogeni zilnic, la locul de munca, sunt mai predispuse sa contracteze o forma de cancer, in special de vezica. Soferii, muncitorii care au de-a face cu cauciucul, cei din industria motoarelor mecanice sau pielarii ori mecanicii trebuie sa se fereasca pe cat posibil si sa isi curete corpul pentru ca sunt mult mai expusi la substante nocive ce pot duce la cresterea celulelor anormale.
Studiile spun ca fructele si legumele de culoare galben-portocalie ajuta foarte mult la reducerea riscului de cancer. Persoanele cu varste peste 40 de ani sunt mai predispuse la captarea bolii, asa cum si barbatii sunt de patru ori mai predispusi la boala decat femeile. Dieta joaca si ea un rol esential, cea bogata in grasimi, nitrati si carne predispunand corpul la intoxicare.
Diagnosticarea cu cancer
Cancerul de vezica poate fi descoperit de medicul urolog, de medicul de familie sau de specialistul in costologie. Pacientii predispusi la cancer si boli de vezica urinara, cei care prezinta semne sau suspiciuni referitoare la cancer trebuie neaparat sa viziteze medicul de specialitate pentru ca suspiciunile acestora sa fie infirmate sau confirmate, dupa caz.
In vederea confirmarii diagnosticului este nevoie de o cistoscopie, operatie prin care un tub subtire si flexibil este introdus prin uretra in vezica urinara si o camera video de la capatul acestuia ofera informatii esentiale pentru specialist.
Daca apar tesuturi ciudate, nenormale, se poate recurge la biopsie (prelevarea de tesut ce va fi mai tarziu examinat la microscop). Nu de putine ori se intampla ca, in urma unui control citoscopic, sa apara semne ale cancerului, fara ca acestea sa fie cautate. Citologia urinei se obtine din urina in urma analizei sau direct in timpul cistoscopiei. Si cu ajutorul cistoscopiei dinamice, cu lumina albastra, se poate afla daca pacientul sufera de cancer de vezica sau nu. Acest procedeu poate fi folosit oricand si ajuta la descoperirea precoce a bolii, putandu-se recurge astfel la tratarea inca din fazele incipiente ale acesteia.
Oricare din aceste metode folosite nu ajuta la determinarea stagiului, tipului cancerului sau patologiei acestuia. Nici biopsia nu ajuta prea mult, singura cale de confirmare 100% a cancerului de vezica este prin chirurgie.
Rezectia transuretrala poate confirma sau infirma aparitia cancerului, astfel ca, in urma acestei operatii, pacientul trebuie sa se reintoarca in cabinetul medicale de doua ori pe an in vederea examinarii tesutului si a eventualei tumori. Prin intermediul rezectiei transuretrale se descopera atat tipologia patologica, cat si stadiul tumorii, aceasta interventie chirurgicala avand o importanta deosebita.
Studiile arata ca nu mai putin de 90% din cancerul de vezica este carcinom de celule tranzitionale. Restul tumorilor sunt adenocarcinoame, carcinoame ale celulelor scuamoase, sarcom, carcinoame de celule mici sau depozite secundare de celule care se pot gasi la nivelul altor organe sau zone critice din corp. Cancerul de vezica urinara este clasificat in mai multe stagii, in fucntie de gradul de dezvoltare, tipologie, gradul de invazie in organism si posibilitatea tratarii.
Tratamentul bolii
Tratamentul cancerului de vezica urinara depinde de gravitatea tumorii, stagiul si patologia sa si localizare. Tumorile superficiale care nu sunt atasate de alte tesuturi importante pot fi eliminate prin ustensila electrocauterizanta care se ataseaza la cistoscop. Aceasta este folosit in cadrul rezectiei transuretrale si, pe langa rolul de analizant al tesutului, detine si rol de tratament in cazul tumorilor simple. Daca tumora este invaziva si a atacat deja si alte organe din corp, in afara de tractul urinar, procedura terapeutica nu este de ajuns in tratarea finala a bolii.
Un tratament al cancerului de vezica este constituit de imunoterapie, metoda care trateaza doar tumorile superficiale. Pentru tumorile fara complicatii, imunoterapia este de obicei cea mai buna solutie, 2/3 din cazurile de tumora superficiala se trateaza. Daca cistectomia nu este o solutie viabila, se poate incerca chimioterapia interna in vederea extirparii sau micsorarii tumorii.
Pacientii ale caror tumori au revenit dupa primul tratament vor avea un risc mai mare de complicare. Cistectomia ramane ultima solutie pentru astfel de pacienti care sufera de recidiva cancerului. Multi bolnavi refuza sa faca aceasta operatie si aleg metodele alternative care au un efect pozitiv la tumora mai putin complicata.
Chimioterapia asistata tehnic ajuta foarte mult in tratamentul cancerului de vezica, facilitandu-se absorbtia substantelor care lupta cu celulele anormale ce iau control asupra tesutului. Pentru un efect cat mai drastic, este nevoie ca substantele folosite sa fie administrate direct in tesutul uretral.
Termoterapia reprezinta o alta forma de tratament a cancerului de la nivelul vezicii urinare. Aceasta metoda terapeutica foloseste frecvente radio care incalzesc vezica urinara. Termoterapia este folosita impreuna cu chimioterapia, astfel ca cele doua tratamente ajuta mult in eradicarea celulelor afectate.
Daca ramane netratat, cancerul de vezica urinara ajunge sa se intinda si peste peretele vezicii. Tumorile care ajung in peretele urinar au nevoie de un tratament mai drastic, in cadrul caruia o parte sau intregul perete vezical este excizat, iar urina se indreapta spre o bucla izolata de intestin care preia rolul vezicii. In cazurile mai complicate, chirurgul poate sa faca o vezica de inlocuire din tesut intestinal, insa aceasta metoda depinde de varsta, dorinta, starea de sanatate si functiile renale ale pacientului.
Cancerul invaziv poate fi tratat si prin combinatie de radioterapie cu chimioterapie. O fuctionalitate nu a fost inca adusa acestui cumul terapeutic, insa chirurgia ablativa radicala functioneaza. Diagnosticul precoce fotodinamic poate ajuta foarte mult in tratarea cancerului.
Pentru cancerul de vezica urotelial muscloinvaziv se poate apela la una sau mai multe dintre metodele de tratament disponibile. Cistectomia radicala este cea mai comuna optiune si cea mai sigura. Aceasta interventie chirugicala este insotita de eliminarea prostatei la barbati si de eliminarea unor parti din vagin, uter si ovare la femei. Diseminarea micrometastazica nu este tot timpul tratata doar cu ajutorul chirurgiei, astfel ca se recurge si la tratamentul neoadjuvant. Acesta consta in terapie ce dureaza pana la cinci ani, terapie compusa din sedinte regulate de chimioterapie.
Epidemii
Cancerul de vezica are o incidenta mare in Statele Unite ale Americii si in Africa de Nord. In cazul acestor imbolnaviri in masa, un rol esential il are fumul de tigara,acesta fiind urmat de receptorii androgini mai activi la barbati.
Cum evitam cancerul
Cancerul de vezica nu poate fi prevenit in niciun fel, sigura solutie fiind reducerea factorilor de risc care duc la aparitia sa:
- Renuntarea la fumat scade intr-o perioada de 1-4 ani incidenta aparitiei cancerului cu pana la 50%
- Inlocuirea produselor cu tutun cu altele, fara substante nocive, ajuta la scaderea riscului contractarii cancerului de vezica.
- Stoparea expunerii organismului la toxice de tip industrial
- Adoparea unei diete alimentare sanatoase (dieta fara grasimi, cu continut mic de colesterol, cu multe legume si fructe).
- Evitarea deshidratarii trebuie sa fie o optiune critica pentru pacient, pentru ca cantitatea ridicata de lichide scade procentul de substante nocive din organism.























